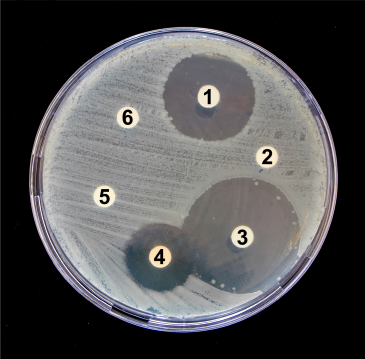
Petri dish showing bacterial growth with six antibiotic discs; zones of inhibition vary around each numbered drug.

When determining the effectiveness of antimicrobial drugs against infections, it is essential to understand how to identify which drugs will work and the appropriate dosage. Two key concepts in this process are the minimal inhibitory concentration (MIC) and the minimal bactericidal concentration (MBC). The MIC is defined as the lowest concentration of an antibiotic that inhibits bacterial growth, meaning it stops bacteria from multiplying but does not necessarily kill them. In contrast, the MBC is the lowest concentration of an antibiotic that kills the bacteria outright.
One common method to assess antibiotic effectiveness is the disk diffusion method, often referred to as the Kirby-Bauer test. This test involves spreading bacteria on an agar plate and placing small paper discs impregnated with different antibiotics on the surface. After incubation, bacterial growth appears as a cloudy area, while clear zones around some discs indicate where bacteria could not grow. These clear areas are called the zone of inhibition, representing regions where the antibiotic concentration was sufficient to prevent bacterial growth.
The size of the zone of inhibition reflects the bacteria's susceptibility to the antibiotic: a larger zone indicates greater susceptibility. For example, if the zone around disc C is larger than that around disc B, the bacteria are more susceptible to the antibiotic on disc C. If there is no zone of inhibition, as with disc A, the bacteria are resistant to that antibiotic. However, while the Kirby-Bauer test shows whether an antibiotic inhibits growth, it does not provide the exact MIC because the antibiotic concentration at the edge of the zone is unknown. Additionally, it cannot determine the MBC, as it is unclear whether bacteria within the zone are dead or merely not growing.
To estimate the MIC more precisely, the E-test (or epsilon test) is used. This method employs a plastic strip with a gradient of antibiotic concentrations placed on an agar plate inoculated with bacteria. After incubation, the zone of inhibition forms an ellipse around the strip. The point where bacterial growth intersects the strip corresponds to the MIC, which can be read directly from the scale on the strip, typically expressed in micrograms per milliliter (\(\mu g/mL\)). This allows for a quantitative measurement of the lowest antibiotic concentration that inhibits bacterial growth.
Despite providing an estimate of the MIC, the E-test still does not reveal whether the antibiotic is bactericidal or merely bacteriostatic. Determining the MBC requires additional testing beyond these diffusion methods. Understanding these tests and their limitations is crucial for selecting effective antimicrobial therapies and appropriate dosages to treat infections successfully.